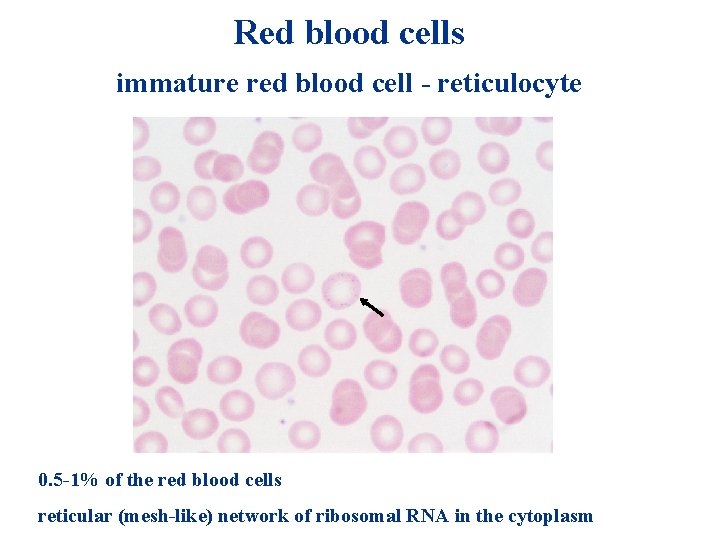
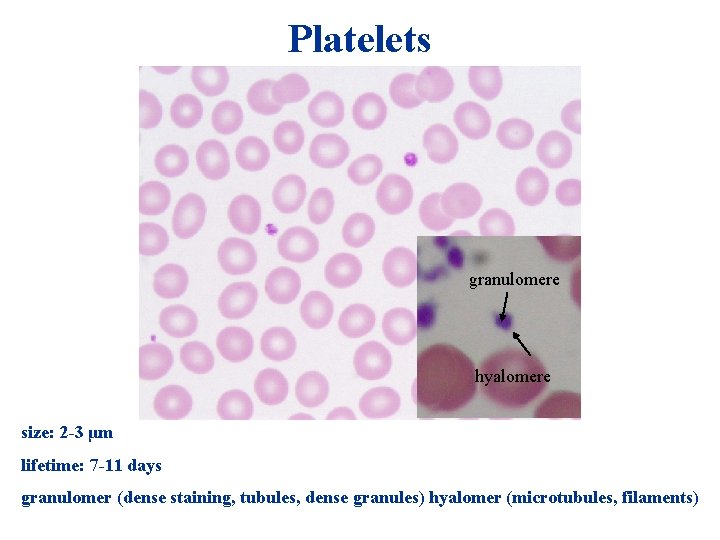
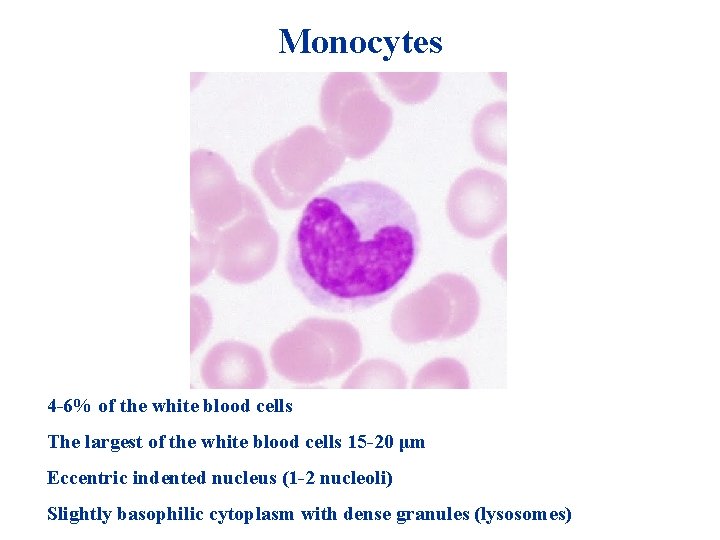
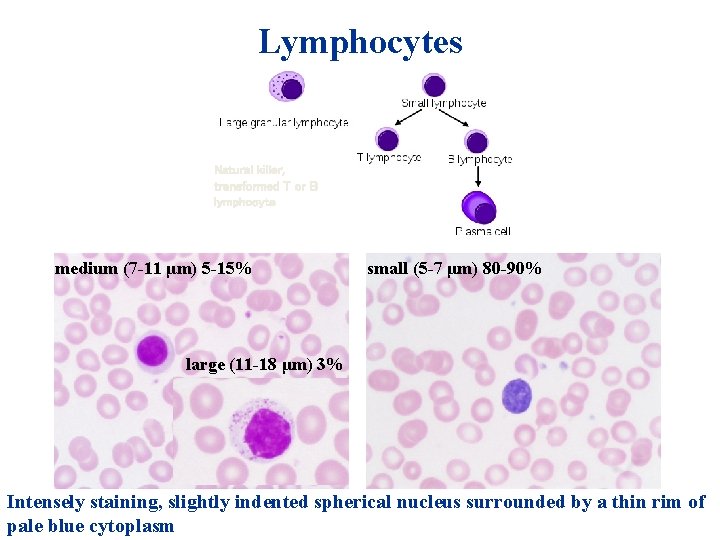
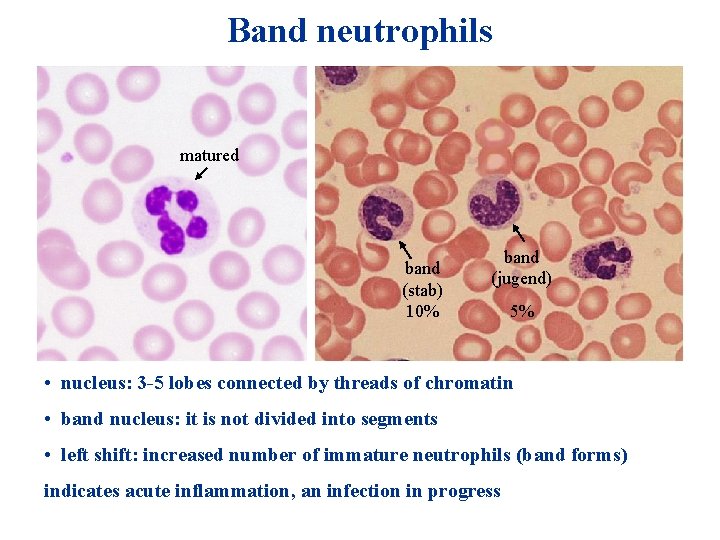

Connective tissue cells and blood cells Dr Zita

Connective tissue cells and blood cells Dr. Zita Puskár EDI 20/10/2017

Composition of connective tissue • Cells • Extracellular matrix (ECM) - Fibers - Macromolecular complexes - Tissue fluid

Stem cells Asymmetric division

Development of connective tissue human and mammals • Connective tissue proper develops from MESENCHYME, the embryonic connective tissue. • Specialized connective tissue also develops from MESENCHYME, except in the head where certain progenitor cells are derived from the ECTODERM.

Mesenchymal cell (mesoblast) Pluripotent cells of the embryonic connective tissue. Shape: irregular, spindle or stellate shaped. Nucleus: round or oval. The processes are interconnected by gap juncrtions. Small number of mesenchymal cells are found also in adults. (Adult stem cells are found in the bone marrow, adipose tissue, dental pulp, endometrium. )

Wharton’s jelly in the umbilical cord Wharton’s jelly is a mucous connective tissue surrounding and protecting the umbilical cord vessels (2 arteries and one vein) against compression, bending twisting etc. It originates from the extraembryonic mesoderm and composed of mesenchymal cells and ECM (collagen, hyaluronan and proteoglycans). Some fibroblasts and macrophages also appear. Hyaluronan makes this tissue highly hydrated, collagen makes it resistant. It is a postnatal source of fetal stem cells.

Connective tissue cells Resident cells (regularly present cells in connective tissue) mesenchymal origin mesenchymal cells (mesoblast) fibroblast-fibrocyte-myofibroblast reticular or adventitial cell adipocytes melanocytes (neural crest) Transient cells (migrate from the blood) differentiate from hemopoetic stem cell mast cell* monocytes →macrophage* lymphocytes → plasma cell* (granulocytes neurotrophil, eosinophil, basophil) * become resident cell


Fibroblast (active form) ECM production → high protein synthesis→ free ribosomes, r. ER és Golgi apparatus → basophil cytoplasm. Round or oval nucleus with nucleolus.

Fibrocyte (inactive form) Fibrocyte is a 15 -20 µm long, elongated cell that attached to the collagen fibres. It has thin eosinophil cytoplasma with dark basophilic nucleus.

Fibroblast and fibrocyte

Fibrocyte transformation into fibroblast Damage → Cytokines (interleukins) produced by macrophage Platelet derived groth factors and cytokines Fibrocyte transformes into fibroblast (division)

Myofibroblast + HIO 4 = • Displays properties of both fibroblast and smooth muscle cell • Contains myofilaments (α-smooth muscle actin) characteristics for smooth muscle cell • Contributes to tissue repair in wound healing • When contraction and ECM protein secretion become excessive → pathological condition (eg. fibrosis)

Reticular (adventitial) cell Specialized fibroblastic cell. Star shaped cell with ovoid nucleus. Production of reticular fibers and ECM (bone marrow, spleen, tonsills, lymph node)

Adipocytes Maintain the homeostasis • Support and padding (shock absorber in the soles and palms) • Long-term energy storage • Secretion Leptin receptor deficient mice Morphology: ≈50 -150 μm unilocular (univacuolar, triglycerides stored in single locus) A thin ring of cytoplasm surrounding the vacuole → signet ring cell

White and brown adipocytes Brown adipoytes are poligonal, smaller than white adipocytes and multilocular (contains a great number of lipid droplets). The nucleus is central or eccentric. It has large number of mitochondria containing colored cytochromes (lipochrom) Main function: heat production During development the tissue disappears or replaced by white adipose tissue. (Remain: interscapular space, kidney, thymus).

Transgenic mice (shown left, marked TG) with overexpressed levels of the Zfp 516 protein gained less weight than their unaltered, wild type (WT) counterparts after both groups were fed a high-fat diet for a month. (Photo by Jon Dempersmier) Mariëtte R Boon, Emmani B M Nascimento & Wouter D van Marken Lichtenbelt (Nature Medicine 21, 667– 668 (2015)

White, beige and brown adipose tissue

Fat soluble dyes Oil red Sudan black

Melanocytes are neural crest origin → migrate into the stratum basale layer of the skin. It has rounded cell body with long dendritic proccesses containing melanin and carotene. In connective tissue of iris, cornea is also found. UV radiation→ melanin production → cytokin secretion → DNA protection

Melanoma

+ HIO 4 =

Functions of blood Transport • Gases (oxygen and carbon dioxide) between the lungs and rest of the body • Nutrients from the digestive tract and storage sites to the rest of the body • Waste products to be detoxified or removed by the liver and kidneys • Hormones to their target cells • Heat to the skin so as to help regulate body temperature Protection • Leukocytes, or white blood cells, destroy invading microorganisms and cancer cells • Antibodies and other proteins destroy pathogenic substances • Platelet factors initiate blood clotting and help minimize blood loss Regulation • p. H by interacting with acids and bases • Water balance by transferring water to and from tissues

Composition of blood 1 mm 3=1μl The hematocrit is the percentage of blood volume that is occupied by red blood cells. Ht (for women) ~ 36 -48 %, (for men) ~ 42 -52%

Formed elements of the blood Red blood cells (erythrocyte) White blood cells (leukocytes) Agranulocytes - mononuclear Lymphocytes Monocytes Granulocytes - polymorphonuclear Neutrophils Eosinophils Basophils Scanning electron microscop image from normal circulating human blood Platelets (thrombocytes) Red blood cells (4 -6 million/mm 3)>Platelets (250 000 -400 000/mm 3)>white blood cells (5000 -9000/mm 3)

Blood smears Staining steps: 1. May-Grünwald solution (methanol - fixative, methylene blue basic dye, eosin - acidic dye) 2. Giemsa solution (azure - basic dye, eosin - acidic dye) Basic dyes stain: cell nuclei, granules of basophils, RNA of the cytoplasm Acid dye stains: red blood cells, granules of eosinophils

Red blood cells (erythrocytes) • shaped as biconcave • engaged in the transport of respiratory gases • eosinophil plasma (proteins, 95% hemoglobin)

Red blood cells (erythrocytes) Scanning electron microscope image of erythrocytes Transmission electron microscope image of an erythrocyte within a blood vessel • lifetime ~ 120 day • do not possess nucleus • lack organelles • perform their functions while they are within the bloodstream

Membrane of the red blood cells • high protein content (glycophorins, band 3) • actin, spectrin, ankyrin → shape, resistance, elasticity • glycocalix – carbohydrates → AB 0 blood system

Hemoglobin Anemia is a decrease in number of red blood cells or less than the normal quantity of hemoglobin in the blood. ( The oxygen-carrying capacity of the blood is, therefore, decreased. )
Red blood cells immature red blood cell - reticulocyte 0. 5 -1% of the red blood cells reticular (mesh-like) network of ribosomal RNA in the cytoplasm
Platelets granulomere hyalomere size: 2 -3 μm lifetime: 7 -11 days granulomer (dense staining, tubules, dense granules) hyalomer (microtubules, filaments)

Functions of Platelets Function: blood clotting, clot retraction, clot dissolution Cytoplasmic constituents related to this functions: • α –granules (clotting factors, PDGF growth factors, platelet factor 4, fibronectin, von Willebrand factor), δ –granules (serotonin, histamine, ADP-, ATP, calcium), λ –granules ( lysosomal enzymes) • microtubules and filaments (actin, myosin) • canalicular system (exocytosis of granules)

Electron microscopy of platelets resting activated

White blood cells (leukocytes) (granulocytes, lymphocytes, monocytes) • are transients within the blood. • use the bloodstream as a vehicle for transport to specific sites • regularly leave the blood through the wall of capillaries and venules to enter the connective tissues, lymphatic tissues and bone marrow. • functions: recognition and elimination of pathogen microorganisms, infected cells, unknown molecules, outside agents
Monocytes 4 -6% of the white blood cells The largest of the white blood cells 15 -20 μm Eccentric indented nucleus (1 -2 nucleoli) Slightly basophilic cytoplasm with dense granules (lysosomes)

Functions of monocytes Monocytes • are precursor cells of the mononuclear phagocyte system (MPS) • leave the blood vessel → transform into a tissue macrophage → participate in the phagocytosis of bacteria and other tissue debris, present antigens to lymphocytes Tissue macrophages: alveolar macrophage (lung), Kupffer cells (liver), Langerhans cells (skin), microglia (CNS), osteoclast (bone), chondroclast (cartilage), Hofbauer cell (placenta)

Connective tissue macrophage (histiocyte) + HIO 4 = Foreign body giant cell Elongated irregular shape – amoeboid wandering nature Difficult to recognize in routine preparations- lack distinguishing characteristics Active macrophage more visible by the indigestible residues (vital dyes)

Functions of macrophage + HIO 4 = phagocytosis as a defense activity (bacteria) as a clean up operation cell debris antigen presentation secretion (cytokines)

Lymphocytes Natural killer, transformed T or B lymphocyte medium (7 -11 μm) 5 -15% small (5 -7 μm) 80 -90% large (11 -18 μm) 3% Intensely staining, slightly indented spherical nucleus surrounded by a thin rim of pale blue cytoplasm

Activation of lymphocytes

Lymphocytes Functions (main functional cells of the lymphatic or immune system) • T lymphocyte (70 -90%) – cell mediated immunity • B lymphocyte (5 -15%) - humoral immune response, Ig production (differentiate into plasma cell) • Natural killer (1 -3%) – killing infected or tumor cells by causing them to lyse (perforin) Development T: thymus, lymphatic organs (T dependent area) B: bone marrow, lymphatic organs (B dependent area)

Plasma cell • Derivatives of B lymphocyte • Active in the production and secretion of antibodies • Cytoplasm contains large amount of r. ER basophilia • The cell is ovoid • Eccentric nucleus • Peripheral heterochromatin alternating with euchromatin → cartwheel appearance Found in • Lamina propria of the gastrointestinal tract • Connective tissue of the respiratory tract Salivary glands


Mast cell + HIO 4 = Mast cells are numerous in skin and mucous membranes, capsule of organs, menings (not within the CNS), Thymus (not in spleen). Ovoid cell with spherical nucleus. Cytoplasm is filled with large membrane limited granules. After glutaraldehyde fixation the granules stain with basic dyes (tolidine blue). (sulphated PG-heparin)

Metachromasia toluidine blue Heparin-sulphated proteoglycan Dyes: • Metilene blue • Toluidine blue • Thionin A phenomenon whereby a dye (such as toluidine blue) changes color after reacting with a tissue component is referred to metachromasia Underlying mechanism → presence of polyanions within the tissue After binding, the dye molecules are sufficiently close to form aggregates whose absorption properties are different from individual dye molecules.

Functions of mast cell + HIO 4 = Antigen-antibody reaction→discharge of histamine, slow reacting substance of anaphylaxis, eosinophil chemotactic factor of anaphylaxis, heparin (degranulation)

Eosinophil granulocytes • 2 -4% • size (diameter) : 12 -17 μm • life span 6 days (at least) • bilobed nucleus • function: fighting viral infections / parasites, acting as mediator of allergic responses, removal of fibrin, phagocytosis of antigen-antibody complexes

Eosinophil granules granule crystalline body diameter of the granules (0, 5 -1, 5 μm) centre of the granules – crystalline body containing major basic protein (MBP) cytotoxic molecule matrix of the granules: RNase, phospholipase, histaminase, arylsulphatase, eosinophil peroxidase (EPO), eosinophil cationic protein (ECP), eosinophil-derived neurotoxin (EDN)

Basophil granulocytes • • • 0, 01 -0, 5 % size (diameter) : 10 -14 μm life span: 3 -10 days belobed nucleus large granules stained with basic dyes contain heparin, histamine, slow reacting substance (SRS) • function: inflammatory reactions (allergic symptoms), prevention of blood clotting too quickly (heparin, SRS), vasodilatation (histamine), release of vasoactive agents , receptor for Ig. E

Neutrophil granulocytes (polymorphonuclear neutrophils, polimorphs) Barr body condensed X cromosome • 60 -70% of the white blood cells • size (diameter) : 8 -10 μm (in blood), 12 -14 μm (in blood smear) • life span about 3 days • segmented nucleus • no specific affinity for acid or basic dyes

Functions of neutrophils azurophil granule specific granule • first response of acute inflammation • phagocytosis (specific granules: antibacterial agents, lysosim, collagenase, alkaline phosphatase, azurophilic granules: eg. myeloperoxidase, lysosomal enzymes, lysosym, defensins)
Band neutrophils matured band (stab) 10% band (jugend) 5% • nucleus: 3 -5 lobes connected by threads of chromatin • band nucleus: it is not divided into segments • left shift: increased number of immature neutrophils (band forms) indicates acute inflammation, an infection in progress

Neutrophil is chasing bacteria
- Slides: 55